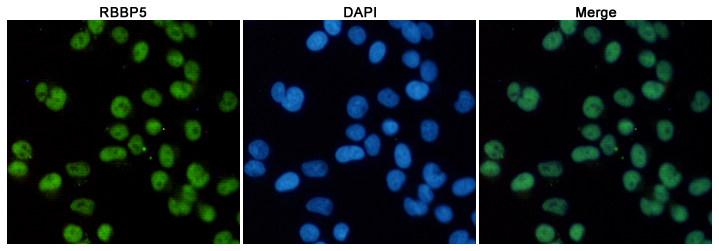

单克隆抗体
RBBP5 Mouse mAb (AB3336)
UniProt:Q15291
Application:WB,ICC/IF
Reactivity:Human,Mouse,Rat
Source:Mouse mAb
RBBP5 Mouse mAb (AB3336)
UniProt:Q15291
Application:WB,ICC/IF
Reactivity:Human,Mouse,Rat
Source:Mouse mAb
http://www.abways.cn/showproduct.asp?cid=AB3336
Leptin Mouse mAb (AB3337)
UniProt:P41159
Application:Elisa
Reactivity:Human
Source:Mouse mAb
http://www.abways.cn/showproduct.asp?cid=AB3337
Leptin Mouse mAb (AB3338)
UniProt:P41159
Application:Elisa
Reactivity:Human
Source:Mouse mAb
http://www.abways.cn/showproduct.asp?cid=AB3338
Vimentin Mouse mAb (AB3339)
UniProt:P08670
Application:WB,ICC/IF,IP
Reactivity:Human
Source:Mouse mAb
Vimentin Mouse mAb (AB3339)
UniProt:P08670
Application:WB,ICC/IF,IP
Reactivity:Human
Source:Mouse mAb
http://www.abways.cn/showproduct.asp?cid=AB3339
Human EGF Mouse mAb (AB3340)
UniProt:P01133
Application:Elisa
Reactivity:Human
Source:Mouse mAb
http://www.abways.cn/showproduct.asp?cid=AB3340

销售咨询
销售咨询 一键电话
一键电话